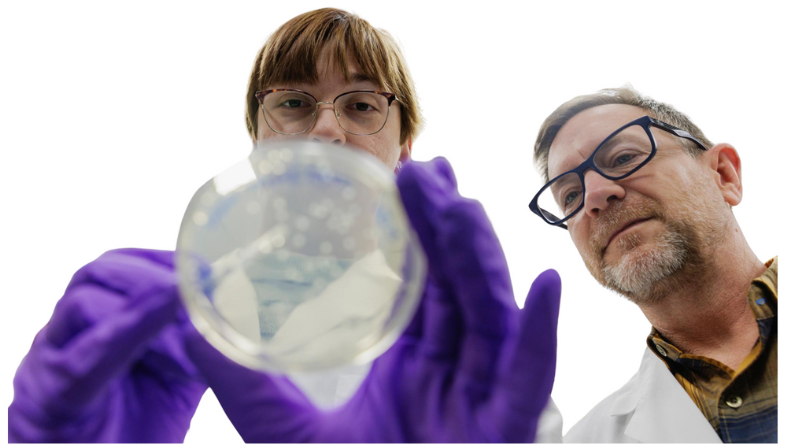
Graduate student Emily Baum, left, works with Tom Barker in his lab.

Research
Driving discovery. Advancing hope.
The Choroideremia Research Foundation (CRF) is committed to accelerating scientific progress toward treatments and a cure for choroideremia (CHM). Through strategic funding, global collaboration, and open data sharing, CRF supports the research community and connects discoveries in the lab to meaningful outcomes for patients and families.







